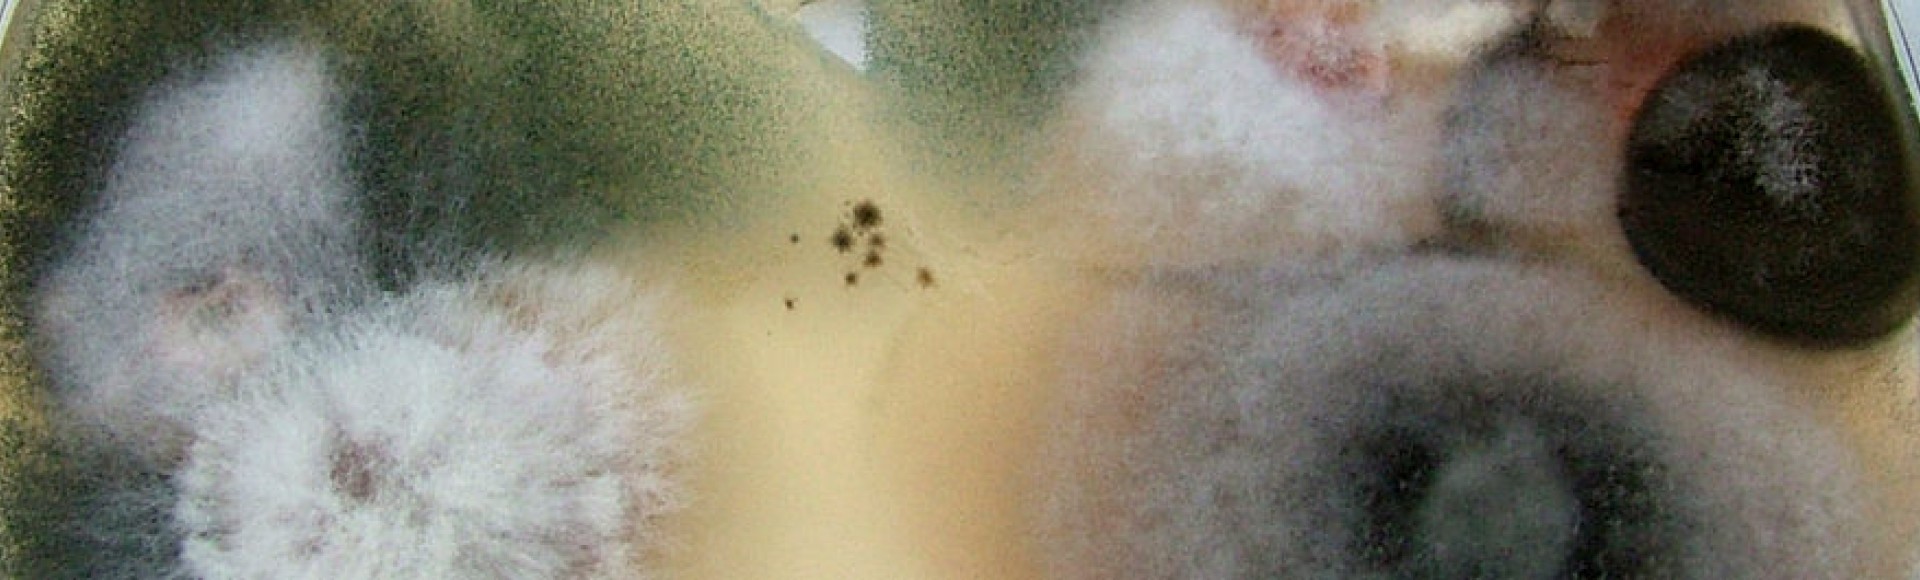
Penészgomba elleni védekezés
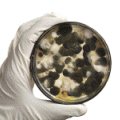
Penészgomba elleni védekezés

PENÉSZGOMBA ELLENI VÉDEKEZÉS
A termék rövid leírása:
 A Sanosil S010 Ag egy használatra kész penészgomba-ölőszer, ami kiváló a penészgomba ellen, ugyanakkor egyszerű és biztonságos a használata. A Sanosil S010 Ag használatakor, illetve használata után sem szabadulnak fel egészségre káros anyagok; csak oxigén (O2) és víz keletkezik. A felületen visszamaradó alkotóelem (ezüst) láthatatlan és nem mérgező, azonban hosszú ideig megakadályozzák a penészgomba ismételt megjelenését. A Sanosil S010 Ag nem rákkeltő, és nem mutagén.
A Sanosil S010 Ag egy használatra kész penészgomba-ölőszer, ami kiváló a penészgomba ellen, ugyanakkor egyszerű és biztonságos a használata. A Sanosil S010 Ag használatakor, illetve használata után sem szabadulnak fel egészségre káros anyagok; csak oxigén (O2) és víz keletkezik. A felületen visszamaradó alkotóelem (ezüst) láthatatlan és nem mérgező, azonban hosszú ideig megakadályozzák a penészgomba ismételt megjelenését. A Sanosil S010 Ag nem rákkeltő, és nem mutagén.
![]() A Sanosil S010 Ag-ra vonatkozó veszélyességi információk:
A Sanosil S010 Ag-ra vonatkozó veszélyességi információk:
- H319: Súlyos szemirritációt okoz.
- P280: Védőkesztyű/védőruha/szemvédő/arcvédő használata kötelező.
- P102: GYERMEKEKTŐL ELZÁRVA TARTANDÓ
- P305+P351: SZEMBE KERÜLÉS ESETÉN: Óvatos öblítés vízzel több percen keresztül.
- P337+P313: Ha a szemirritáció nem múlik el: orvosi ellátást kell kérni.
- P501: A tartalom/edény elhelyezése hulladékként: a helyi előírásoknak megfelelően.
A gomba/penészgomba spórákon kívül a Sanosil S010 Ag bizonyítottan nagyon hatásos a baktériumokkal (beleértve a spóraképzőket), vírusokkal, élesztőgombákkal, valamint a protozoonokkal és algákkal szemben is.
A termék hatóanyaga a hidrogén-peroxid, amit stabilizálunk, és a mikroorganizmusok elleni hatékonyságát ezüst hozzáadásával javítjuk. Így az egyszerű hidrogén-peroxidhoz képest többszörös biocid hatást tudunk elérni.
Segédeszközök:
A Sanosil S010 Ag penészgomba-ölőszer használatakor ajánlott az alábbi védőfelszerelés és segédeszközök használata:
- Védő felszerelés készlet a penész biztonságos megszüntetéséhez, ez a következőkből áll: (védőszemüveg, porvédő maszk lehetőleg szeleppel ellátva, védőkesztyű)
- Permetező készülék vagy kézi permetező. (Ezek a termékek a Sanosil Hungária Kft-nél beszerezhetők.)
- A penész oka lehet a magas páratartalom. Használjon páramentesítő készüléket.
- A gombaspórák (és más apró szennyeződések) kiszűrése a szoba levegőjéből gátolja a penész terjedését és javítja a közérzetet. (Főként allergiások számára.)
A termékleírás pdf formátumban letölthető.
További információt a www.peneszvedelem.hu oldalon talál.
 Helyszíni vizsgálat és szaktanácsadás
Helyszíni vizsgálat és szaktanácsadás